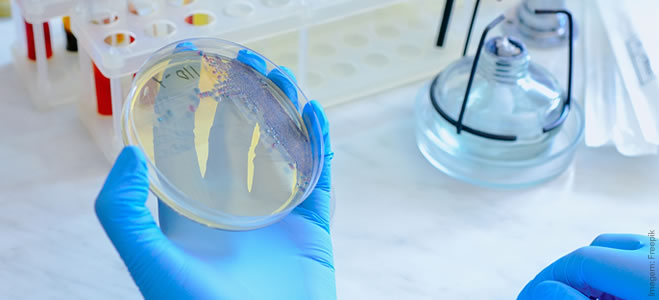

A demanda por soluções que promovam a saúde e o bem-estar tem colocado os bióticos em evidência, impactando positivamente os produtos alimentícios e a saúde dos consumidores.
O conceito de bióticos, que tem como principais representantes os probióticos, prebióticos e pós-bióticos, tem suas origens no início do século XX, embora a relação entre a saúde intestinal e o bem-estar humano seja muito mais antiga. Em 1907, o cientista russo Élie Metchnikoff, prêmio Nobel de Medicina, propôs que os microrganismos presentes no intestino humano poderiam influenciar diretamente a saúde, assim como algumas bactérias benéficas poderiam, inclusive, promover a longevidade. Essa teoria inovadora foi o primeiro grande passo para a compreensão da importância dos probióticos na dieta.
As pesquisas sobre bactérias benéficas começaram a se intensificar na década de 1950, com a identificação de cepas específicas, como Lactobacillus acidophilus e Bifidobacterium bifidum, capazes de colonizar o intestino e oferecer benefícios à saúde digestiva. O uso desses microrganismos na alimentação, especialmente em produtos lácteos fermentados, como o iogurte, ganhou popularidade, impulsionando o conceito de “alimentos vivos”, hoje conhecidos como probióticos.
Com a intensificação dos estudos, nos anos de 1990, surgiu o conceito de prebióticos, descritos como substâncias alimentares não digeríveis que estimulam o crescimento ou a atividade de microrganismos benéficos no intestino, complementando os probióticos.
O termo “prebiótico” foi cunhado em 1995, por Glenn Gibson e Marcel Roberfroid, dois renomados cientistas na área de microbiologia e nutrição, marcando o início da aplicação prática dessa categoria, com destaque para a inulina e os frutooligossacarídeos (FOS).
A partir de então, os prebióticos começaram a ser incorporados em uma ampla gama de produtos alimentícios, de cereais a barras de granola, devido aos seus efeitos benéficos na saúde digestiva, controle de peso e absorção de minerais. Sua presença nos alimentos também veio acompanhada do aumento no foco das indústrias de saúde e nutrição sobre a importância da alimentação funcional, ou seja, alimentos que não apenas nutrem, mas também impactam positivamente a saúde.
Os estudos sobre os efeitos metabólicos dos probióticos levou à descoberta dos pós-bióticos. Na década de 2000, cientistas perceberam que, além de organismos vivos, os produtos do metabolismo bacteriano, como ácidos graxos de cadeia curta e peptídeos antimicrobianos, também poderiam oferecer benefícios significativos para a saúde, levando ao reconhecimento dos pós-bióticos como substâncias bioativas que podem ser usadas como ingredientes em alimentos funcionais, oferecendo vantagens substanciais, especialmente pela sua estabilidade. Enquanto os probióticos exigem condições específicas de armazenamento e manipulação para manter sua viabilidade, os pós-bióticos não possuem a mesma fragilidade, o que os torna opções estáveis e eficazes para uma variedade de alimentos e bebidas.
Os avanços na ciência do microbioma impulsionaram a criação de novas categorias de bióticos, abrindo um leque de oportunidades para produtos mais sofisticados e direcionados. Simbióticos (combinações cientificamente formuladas de probióticos e prebióticos, desenvolvidas para atuar em sinergia), parabióticos (células microbianas inativadas que, mesmo não estando vivas, mantêm propriedades benéficas), metabióticos (compostos bioativos derivados do metabolismo de probióticos) e eubióticos (integração de soluções como probióticos, prebióticos, simbióticos e outros compostos bioativos), são alguns exemplos que surgiram em um contexto de crescente demanda por soluções que atendam às necessidades de consumidores em busca de saudabilidade e bem-estar.
Acompanhando a demanda
Com um cenário repleto de inovações e oportunidades, o mercado global de bióticos segue crescendo em ritmo acelerado, focado nos principais e mais relevantes tipos, ou seja, probióticos, prebióticos e pós-bióticos.
De acordo com dados recentes da Grand View Research, somente o mercado global de probióticos foi avaliado em US$ 62,8 bilhões em 2023, apresentando uma taxa de crescimento anual composta (CAGR) projetada de 7,6% até 2030, podendo alcançar aproximadamente US$ 113 bilhões em 2030.
Prebióticos e pós-bióticos seguem trajetórias semelhantes. A Mordor Intelligence aponta que o mercado global de prebióticos deve crescer de US$ 5,9 bilhões em 2023, para US$ 8,6 bilhões em 2028, com uma CAGR de 6,9%. Já os pós-bióticos têm crescimento projetado de 11,3% ao ano, conforme relatado pela Future Market Insights, e podem atingir US$ 24 bilhões globalmente até 2030.
Na América Latina, o mercado de bióticos tem mostrado crescimento acima da média global, impulsionado por países como Brasil, México e Argentina. Dados da Euromonitor International indicam que o mercado de probióticos na região movimentou cerca de US$ 4 bilhões em 2023, e deve alcançar US$ 5,2 bilhões até 2027, com uma CAGR de 6%.
O mercado de prebióticos, por sua vez, tem uma CAGR estimada em 7,2%, passando de US$ 800 milhões em 2023, para cerca de US$ 1,2 bilhão em 2028. No caso dos pós-bióticos, as estimativas da Allied Market Research sugerem que a região experimentará crescimento de 13% ao ano, alinhado ao aumento na demanda por produtos funcionais e suplementos.
No Brasil, o interesse por bióticos cresce na esteira de campanhas de conscientização sobre saúde intestinal e a popularidade de alimentos funcionais. Segundo a Mintel, o mercado brasileiro de probióticos apresentou aumento de 9% em vendas no varejo em 2023, alcançando US$ 1,8 bilhão. Projeções indicam que esse mercado pode ultrapassar US$ 2,4 bilhões até 2027, com uma CAGR de 7,2%.
O setor de prebióticos e pós-bióticos tem ganhado força, especialmente em categorias como iogurtes, kombuchas e barras nutricionais. Dados da NielsenIQ apontam que o mercado de prebióticos deve crescer 8% ao ano, enquanto os pós-bióticos podem atingir crescimento anual de 15%, devido ao crescente interesse por produtos com benefícios de saúde comprovados.
Projeções da Allied Market Research indicam que os bióticos continuarão sendo protagonistas na formulação de alimentos e bebidas. Probióticos encapsulados, prebióticos extraídos de fontes sustentáveis e pós-bióticos com benefícios cientificamente comprovados estão entre as tendências que devem moldar o mercado global nos próximos anos, impulsionando a demanda por alternativas saudáveis e sustentáveis.
Equilíbrio saudável
Nos últimos anos, a ciência tem lançado luz sobre o papel crítico do microbioma na manutenção da saúde e no bem-estar. Esse ecossistema microscópico, composto por trilhões de microrganismos que habitam o corpo humano, especialmente o intestino, desempenha funções essenciais que vão desde a digestão até a regulação do sistema imunológico.
No centro dessa relação simbiótica, ingredientes como probióticos, prebióticos e pós-bióticos surgiram como estratégias avançadas para a formulação de produtos inovadores na indústria de alimentos e bebidas.
Os probióticos, microrganismos vivos que, quando consumidos em quantidades adequadas, proporcionam benefícios à saúde do hospedeiro, principalmente por meio da modulação da microbiota intestinal, se consolidaram como um dos pilares mais importantes na indústria de alimentos e bebidas funcionalmente enriquecidos. A ideia de consumir alimentos para melhorar a saúde intestinal e geral não é nova, mas nos últimos anos, a demanda por probióticos e suas aplicações atingiu um patamar sem precedentes.
Embora a ciência sobre probióticos tenha evoluído consideravelmente desde as primeiras descobertas, o conceito continua a ser centrado na ideia de que esses microrganismos benéficos promovem um equilíbrio saudável entre as bactérias no intestino, impactando diretamente o sistema digestivo e imunológico, o bem-estar geral e, inclusive, a saúde íntima feminina.
Sua aplicação em diversas categorias de produtos na indústria alimentícia é vasta e contínua, refletindo a diversidade das formas de consumo e das necessidades do consumidor.
Os probióticos encontram seu habitat mais tradicional em laticínios fermentados, como iogurtes, leites fermentados e kefir. Cepas como Lactobacillus acidophilus, Bifidobacterium lactis e Streptococcus thermophilus são frequentemente utilizadas por sua compatibilidade com o processo de fermentação e sua capacidade de conferir benefícios à saúde, como a melhora da saúde intestinal e o fortalecimento do sistema imunológico. A adição desses microrganismos pode ser feita diretamente na fermentação ou por meio de técnicas de microencapsulação, que garantem maior estabilidade durante o armazenamento.
Do ponto de vista sensorial, os laticínios fermentados apresentam um perfil que se adapta bem às notas ácidas geradas por algumas cepas probióticas, contribuindo para uma experiência organoléptica equilibrada e agradável.
No mercado de bebidas funcionais, como kombuchas, águas probióticas e sucos fortificados, os desafios técnicos são maiores, devido a necessidade de estabilidade em matrizes líquidas e não fermentadas. Cepas robustas, como Lactobacillus plantarum e Bacillus coagulans, são comumente empregadas por sua resistência ao processamento térmico e à acidez; geralmente, os probióticos são adicionados após a pasteurização, para garantir sua viabilidade, ou encapsulados para maior proteção.
A preservação das características organolépticas é essencial nesse segmento, uma vez que as bebidas precisam manter sua refrescância e evitar sabores residuais indesejados. O consumo regular de bebidas funcionais é associado a benefícios como a regulação da microbiota intestinal e a redução de processos inflamatórios.
Em produtos plant-based, como iogurtes à base de soja, aveia ou amêndoas, os probióticos desempenham papel fundamental na agregação de valor funcional. Cepas como Lactobacillus rhamnosus e Bifidobacterium longum são frequentemente utilizadas, pois se adaptam bem a essas matrizes vegetais e oferecem benefícios como suporte ao sistema imunológico e melhora da digestão.
No entanto, as bases vegetais apresentam desafios específicos, como a necessidade de ajustar o perfil de sabor para mascarar notas amargas que podem ser acentuadas pela adição de probióticos. A microencapsulação é uma estratégia recorrente para assegurar a estabilidade dos microrganismos durante o prazo de validade, preservando, ao mesmo tempo, as características sensoriais.
Outra aplicação relevante está nos snacks enriquecidos, como barras de cereais e biscoitos, que oferecem uma maneira conveniente de consumo diário de probióticos. As cepas mais utilizadas nesse segmento incluem Bacillus coagulans e Lactobacillus casei, conhecidas por sua resistência ao calor e ao processamento mecânico. Os probióticos são geralmente incorporados em fases finais da produção ou por meio de pós encapsulados, que evitam a degradação durante o cozimento.
Sensorialmente, a incorporação de probióticos em snacks tende a ser neutra, garantindo que o produto final mantenha sua textura e sabor característicos. No campo dos benefícios à saúde, esses produtos são valorizados por promoverem a saúde digestiva e contribuírem para o equilíbrio da microbiota de forma prática e acessível.
Em suplementos alimentares, como cápsulas, pós solúveis e sachês, os probióticos são formulados para oferecerem alta concentração e eficácia. Cepas como Lactobacillus reuteri e Bifidobacterium breve são frequentemente escolhidas por sua estabilidade e comprovação científica quanto a benefícios específicos, como melhora de sintomas da síndrome do intestino irritável e modulação da resposta imunológica.
Diferentemente de alimentos e bebidas, os suplementos não enfrentam os mesmos desafios organolépticos, mas exigem rigor no controle de viabilidade ao longo do prazo de validade e no cumprimento de regulamentações que garantam a precisão das alegações de saúde.
Independentemente da categoria de aplicação, o uso de probióticos requer um equilíbrio cuidadoso entre funcionalidade, estabilidade e experiência sensorial. A escolha da cepa e a forma de adição devem considerar não apenas o benefício funcional desejado, mas também os desafios tecnológicos e regulatórios específicos de cada matriz.
Potencializando saúde intestinal e funcionalidade sensorial
De forma simples, os prebióticos são substâncias alimentares que estimulam seletivamente o crescimento ou a atividade de microrganismos benéficos no intestino, com efeito positivo na saúde do hospedeiro. Embora frequentemente associados aos probióticos, desempenham papel fundamental em promover um ambiente saudável para as bactérias benéficas do intestino, estimulando o crescimento e a atividade dessas microbactérias.
São amplamente utilizados na formulação de alimentos e bebidas para atender a demanda por produtos funcionais e saudáveis em diversas categorias de aplicação, cada uma com suas particularidades em termos de fontes, formas de adição, impactos sensoriais e benefícios à saúde.
Ingredientes prebióticos como a inulina, frutooligossacarídeos (FOS) e galactooligossacarídeos (GOS) são amplamente utilizados em iogurtes, leites e outros laticínios fermentados. Geralmente obtidos de fontes vegetais, como chicória e beterraba, são adicionados diretamente durante a formulação para complementar os probióticos, criando um efeito sinérgico conhecido como simbiótico.
Sensorialmente, podem influenciar de forma positiva a textura, conferindo maior cremosidade e um perfil de doçura suave, que reduz a necessidade de açúcares adicionados. O seu consumo regular é associado ao equilíbrio da microbiota intestinal e a melhora da absorção de minerais, como cálcio e magnésio, fortalecendo a saúde óssea.
Já em bebidas funcionais, como águas enriquecidas, sucos e bebidas energéticas, os prebióticos apresentam desafios técnicos relacionados à solubilidade e estabilidade. Ingredientes como a fibra de acácia e frutooligossacarídeos são frequentemente utilizados devido a sua alta solubilidade em matrizes líquidas e a capacidade de permanecerem estáveis em condições de pH ácido. Sua adição pode ocorrer diretamente na formulação líquida ou por meio de pós solúveis em etapas finais do processo.
Sensorialmente, contribuem para um corpo mais robusto nas bebidas, sem comprometer a clareza ou o sabor. Os benefícios à saúde incluem a promoção de um ambiente intestinal equilibrado, com impactos positivos no sistema imunológico e na redução de inflamações.
Em produtos plant-based, os prebióticos oferecem um diferencial competitivo, agregando funcionalidade e saudabilidade a alternativas ao leite, iogurtes vegetais e snacks à base de proteínas vegetais, entre outros produtos. Ingredientes como inulina, galactooligossacarídeos e amido resistente, são utilizados para melhorar a textura e mascarar possíveis notas residuais amargas das bases vegetais.
Sua adição, geralmente realizada durante a mistura inicial dos ingredientes, também contribui para a estabilidade do produto e melhoria do perfil sensorial, resultando em maior cremosidade e suavidade. No campo dos benefícios, ajudam na manutenção da saúde intestinal, especialmente em consumidores que seguem dietas ricas em proteínas vegetais, frequentemente associadas a desafios digestivos.
Em produtos panificados, os prebióticos, como inulina e oligofrutose, desempenham papel importante na produção de pães, bolos e biscoitos, tanto com relação a funcionalidade quanto a saudabilidade. Podem ser adicionados diretamente às massas, onde contribuem para a retenção de umidade, melhorando a textura e prolongando a vida útil do produto. Sensorialmente, ajudam a reduzir o uso de açúcares e gorduras, sem prejudicar o sabor e a maciez.
Do ponto de vista da saúde, auxiliam no controle glicêmico e no aumento da saciedade, tornando esses produtos mais atrativos para consumidores preocupados com o bem-estar.
Os prebióticos no formato de pós, cápsulas ou sachês são ideais para adição em suplementos alimentares, sendo, muitas vezes, combinados com probióticos para criar produtos simbióticos de alta funcionalidade. Ingredientes como frutooligossacarídeos, galactooligossacarídeos e polidextrose são os mais comuns, escolhidos por sua pureza e eficácia comprovada.
Esses produtos são formulados para oferecer concentrações precisas de fibras prebióticas, sem impacto sensorial, uma vez que são consumidos isoladamente ou diluídos em água. Os benefícios são diversos, incluindo a melhora da função intestinal, promoção da saúde metabólica e suporte à saúde cardiovascular.
Assim como os probióticos, o uso de prebióticos nas formulações exige equilíbrio técnico entre funcionalidade e experiência sensorial, além de atender às regulamentações de saúde e alegações funcionais.
Benefícios com estabilidade e versatilidade
Os pós-bióticos, metabólitos resultantes do metabolismo de microrganismos benéficos, surgiram como uma solução inovadora para a formulação de alimentos e bebidas funcionais, oferecendo benefícios à saúde semelhantes aos dos probióticos, mas com vantagens adicionais em termos de estabilidade, segurança e facilidade de aplicação. Essas características os tornam cada vez mais atrativos para diversas categorias de produtos, com adaptações específicas para atender às demandas sensoriais e funcionais de cada segmento.
São frequentemente incorporados como alternativas ou complementos aos probióticos em laticínios fermentados. Cepas como Lactobacillus paracasei e Bifidobacterium breve, que produzem metabólitos bioativos durante a fermentação, são utilizadas para gerar compostos pós-bióticos, como ácidos graxos de cadeia curta, exopolissacarídeos e peptídeos antimicrobianos. A adição pode ocorrer diretamente no produto final, após a pasteurização, garantindo estabilidade e eficácia sem comprometer a textura ou o sabor.
Sensorialmente, não alteram significativamente as características organolépticas, mas podem contribuir para uma sensação mais cremosa. Do ponto de vista funcional, oferecem benefícios como suporte imunológico, redução de inflamações e regulação do microbioma intestinal.
Os pós-bióticos se destacam em bebidas funcionais por sua excelente estabilidade em condições adversas de pH e temperatura. Metabólitos produzidos por cepas como Lactobacillus plantarum e Lactobacillus casei são comumente utilizados, sendo adicionados em pó ou líquidos concentrados na etapa final da formulação.
Por serem metabolicamente ativos, os pós-bióticos não dependem de condições de refrigeração para manter sua funcionalidade, o que amplia as possibilidades de aplicação em bebidas refrigeradas e de longa vida. Sensorialmente, são neutros, permitindo que os sabores naturais da matriz do produto sejam preservados. Entre os benefícios à saúde, estão a melhora da barreira intestinal, modulação do sistema imunológico e proteção contra patógenos.
Cepas como Lactobacillus fermentum, que produzem compostos antioxidantes e exopolissacarídeos, são frequentemente escolhidas para enriquecer alternativas ao leite, queijos vegetais e iogurtes à base de plantas, entre outros produtos do segmento plant-based.
A incorporação é feita durante o processamento, geralmente em pó microencapsulado para garantir estabilidade e distribuição uniforme. Sensorialmente, ajudam a equilibrar notas amargas e a melhorar a textura, criando uma experiência sensorial mais agradável. Os benefícios incluem suporte digestivo, redução do estresse oxidativo e promoção de uma microbiota saudável, fatores especialmente importantes para consumidores que buscam dietas à base de vegetais.
Em snacks funcionais, como barras de cereais e biscoitos, os pós-bióticos são uma solução viável devido a sua estabilidade térmica durante o processamento. Metabólitos derivados de Lactobacillus rhamnosus e Bacillus coagulans são amplamente utilizados, sendo adicionados em forma de pó na etapa de mistura dos ingredientes secos. Não alteram o sabor ou a textura dos snacks, o que facilita sua aplicação em formulações já estabelecidas.
Os benefícios à saúde incluem a regulação do sistema imunológico, suporte ao metabolismo energético e promoção de um ambiente intestinal equilibrado.
Os pós-bióticos são cada vez mais populares em suplementos alimentares, devido a sua facilidade de formulação e benefícios cientificamente comprovados. Compostos produzidos por cepas como Lactobacillus reuteri e Bifidobacterium longum são utilizados em cápsulas, comprimidos ou sachês, não apresentando impacto sensorial, já que são projetados para consumo direto ou diluição em líquidos. Os benefícios à saúde incluem redução de sintomas relacionados à síndrome do intestino irritável, modulação da resposta inflamatória e suporte geral à saúde imunológica.
A aplicação de probióticos, prebióticos e pós-bióticos em formulações de alimentos e bebidas representa uma evolução significativa na busca por produtos que aliem inovação, funcionalidade e benefícios à saúde.
Cada uma dessas categorias oferece vantagens únicas, permitindo atender às demandas dos consumidores por opções que promovam o bem-estar de forma prática e saborosa. Além de contribuírem para a saúde intestinal, imunológica e metabólica, esses ingredientes proporcionam flexibilidade de aplicação em diferentes matrizes alimentares, sem comprometer as características organolépticas dos produtos, agregando valor às formulações com saudabilidade e funcionalidade.
Avanços na produção e aplicação
Nos últimos anos, avanços significativos em tecnologias de produção e pesquisas científicas vêm transformando a forma como os bióticos são desenvolvidos e aplicados, garantindo maior eficácia, estabilidade e sustentabilidade em produtos voltados ao consumidor final.
A fermentação de precisão tem se consolidado como uma das tecnologias mais disruptivas na produção de probióticos, trazendo avanços significativos em eficiência, especificidade e sustentabilidade.
Baseada em princípios de biologia sintética e engenharia metabólica, essa técnica permite manipular microrganismos com alta precisão, resultando em cepas probióticas otimizadas para atender a demandas específicas da indústria de alimentos e bebidas. Diferentemente dos métodos convencionais, que dependem de processos naturais menos previsíveis, a fermentação de precisão possibilita o controle detalhado de cada etapa da produção, do design genético ao ambiente de cultivo.
O diferencial dessa tecnologia está na capacidade de programar microrganismos para produzir compostos bioativos ou melhorar sua resistência às condições adversas durante o processamento de alimentos ou no trato gastrointestinal. Cepas desenvolvidas por meio de fermentação de precisão podem, por exemplo, ser projetadas para resistir a altas temperaturas, níveis elevados de acidez ou períodos prolongados de armazenamento. Essa capacidade não apenas amplia o leque de aplicações dos probióticos, mas também reduz as perdas durante a cadeia produtiva, garantindo maior eficácia funcional no produto final.
Um dos focos recentes está na seleção e personalização de cepas probióticas para atender a nichos específicos de mercado. Por meio de ferramentas de sequenciamento genômico e edição de genes, é possível criar microrganismos com propriedades direcionadas, como a produção de metabólitos específicos, modulação da resposta imunológica ou melhora na digestão de nutrientes. Além disso, avanços em bioinformática e modelagem computacional permitem prever com maior precisão o desempenho dessas cepas no organismo humano, reduzindo o tempo de desenvolvimento e o custo de experimentação.
A produção de cepas microbianas altamente específicas está expandindo o potencial dos probióticos para além das categorias tradicionais. Com maior estabilidade, eficácia comprovada e benefícios direcionados, estão se tornando componentes-chave em produtos que combinam funcionalidade com inovação.
Um exemplo é o segmento de snacks funcionais, onde estão sendo incorporados em formatos como barras de cereais, chips e bolachas, trazendo benefícios à saúde intestinal sem comprometer a textura ou o sabor. Graças aos avanços em microencapsulação e à resistência aprimorada das cepas, esses ingredientes podem ser incorporados em produtos secos e com prazos de validade prolongados, superando barreiras técnicas que antes limitavam sua aplicação.
Outra aplicação inovadora está no mercado de bebidas plant-based. Nesse setor altamente competitivo, a adição de probióticos de precisão em leites vegetais, smoothies ou chás fermentados se torna um diferencial; a possibilidade de personalizar os benefícios funcionais das cepas, como melhora da imunidade ou promoção de bem-estar emocional, permite o atendimento de demandas específicas dos consumidores. Além disso, abrem caminho para o desenvolvimento de produtos voltados para a saúde mental, um dos principais focos da indústria de bem-estar.
O setor de produtos plant-based também se beneficia dessa tecnologia para melhorar sabor, textura e perfil nutricional. Cepas específicas podem ser utilizadas para reduzir notas residuais indesejadas de proteínas vegetais, enquanto promovem a fermentação natural de queijos e iogurtes veganos, conferindo maior autenticidade ao produto final. Essas aplicações tornam os alimentos plant-based mais atrativos para um público mais amplo, indo além do nicho de consumidores veganos.
A fermentação de precisão também tem viabilizado o uso de probióticos em fórmulas infantis e alimentos para a terceira idade, segmentos que exigem alta segurança e eficácia comprovada. Cepas projetadas para promover a digestão de nutrientes específicos, como lactose ou proteínas, têm sido incorporadas em produtos destinados a essas populações, atendendo às suas necessidades nutricionais particulares. A adição de probióticos em fórmulas infantis, por exemplo, está sendo explorada para fortalecer o sistema imunológico de bebês, especialmente aqueles que não são amamentados.
No campo dos produtos farmacêuticos e nutracêuticos, os probióticos de precisão estão sendo integrados em novas plataformas de entrega, como cápsulas e gomas, com benefícios direcionados a condições específicas de saúde, como controle glicêmico, redução do colesterol e suporte à saúde vaginal. A capacidade de produzir cepas com propriedades específicas para essas condições amplia as oportunidades de inovação e permite uma comunicação mais clara dos benefícios ao consumidor final.
Outra tecnologia que vem inovando a produção de bióticos é a modificação enzimática, destacando-se, mais especificamente, na produção de prebióticos de alta qualidade, como oligossacarídeos, frutooligossacarídeos e galactooligossacarídeos.
Diferente da fermentação de precisão, que utiliza microrganismos geneticamente modificados para produzir moléculas específicas, a modificação enzimática usa enzimas específicas para transformar ou melhorar moléculas já existentes, sem alterar geneticamente os microrganismos, ou seja, catalisam reações altamente controladas, permitindo a obtenção de compostos com estruturas precisas, elevada pureza e funcionalidade otimizada. O uso de enzimas, como transferases e hidrolases, é particularmente eficiente na criação de ligações glicosídicas únicas, essenciais para a bioatividade dos prebióticos, ao mesmo tempo em que minimiza a formação de subprodutos indesejados.
Os frutooligossacarídeos, por exemplo, são obtidos a partir da modificação enzimática da sacarose por meio da ação de enzimas como a frutofuranosidase, que adiciona unidades de frutose à molécula. Esse processo resulta em oligossacarídeos com tamanhos variados, conhecidos por promover o crescimento de bactérias benéficas no intestino, como as bifidobactérias.
A vantagem do uso da modificação enzimática é a capacidade de controlar o grau de polimerização dos frutooligossacarídeos, ajustando suas propriedades funcionais para diferentes aplicações na indústria de alimentos e bebidas. Produtos como barras de cereais, leites fermentados e bebidas funcionais frequentemente utilizam esse prebiótico para melhorar a saúde intestinal, além de oferecer benefícios como redução do teor calórico e aumento da estabilidade sensorial.
Os galactooligossacarídeos, por sua vez, são produzidos por meio da ação de enzimas β-galactosidases sobre a lactose, gerando estruturas galactosídicas que não são digeridas pelo organismo humano, mas que servem como substrato para microrganismos probióticos. Nesse contexto, a modificação enzimática permite a obtenção de galactooligossacarídeos com perfis de oligômeros específicos, otimizados para diferentes faixas etárias e condições de saúde. Um exemplo são os galactooligossacarídeos com menor grau de polimerização, amplamente utilizados em fórmulas infantis, devido a sua capacidade de mimetizar os oligossacarídeos presentes no leite materno, promovendo um desenvolvimento intestinal saudável em bebês.
A modificação enzimática também está sendo explorada na criação de novos tipos de oligossacarídeos com funcionalidades específicas, como resistência a condições gastrointestinais adversas ou propriedades antioxidantes adicionais. Esses avanços têm permitido à indústria atender a demanda crescente por prebióticos personalizados, alinhados às tendências de saúde e bem-estar, além de ampliar o seu uso em categorias como produtos plant-based e snacks saudáveis.
Outra aplicação da modificação enzimática é na produção de pós-bióticos, alterando suas propriedades para torná-los mais eficazes e estáveis em formulações alimentícias. O aprimoramento dos processos de purificação, como ultrafiltração e cromatografia, tem permitido a obtenção de pós-bióticos de alta pureza, essenciais para aplicações em alimentos e nutracêuticos.
A utilização de tecnologias avançadas de fermentação, como fermentação controlada de alta precisão, tem permitido a produção de pós-bióticos específicos, ajustando variáveis como pH e temperatura para otimizar a geração de compostos com propriedades anti-inflamatórias, antioxidantes e imunomoduladoras. Biorreatores de última geração, com sensores e sistemas automatizados, estão sendo cada vez mais utilizados para garantir uma produção eficiente e consistente desses metabólitos.
Além disso, a cofermentação, que envolve o uso de diferentes microrganismos no mesmo processo, está sendo explorada para criar pós-bióticos com efeitos sinérgicos, oferecendo benefícios ampliados à saúde.
Tendências do mercado contemporâneo
A busca por saúde e bem-estar continua impulsionando o mercado de alimentos e bebidas, criando soluções alinhadas às demandas do consumidor. A personalização nutricional é uma das tendências mais promissoras. Ao focar nas características específicas de cada consumidor, pode combinar bióticos de maneira a otimizar os benefícios para a saúde de acordo com o perfil único do microbioma de cada indivíduo. Essa abordagem implica que os produtos alimentícios e suplementos podem ser formulados com doses e tipos específicos de bióticos que atendem diretamente aos desequilíbrios microbianos e às necessidades nutricionais, criando soluções mais eficazes.
O uso de bióticos também tem se mostrado uma resposta valiosa para atender a consumidores com restrições alimentares, como veganos e pessoas com intolerância ao glúten. Em dietas veganas, a utilização de fontes vegetais de probióticos e prebióticos tem se expandido, proporcionando alternativas eficazes para manter o equilíbrio da microbiota intestinal sem a necessidade de ingredientes de origem animal. Já em produtos sem glúten, os prebióticos e probióticos podem atuar não apenas no suporte à digestão, mas também na promoção de uma microbiota intestinal saudável, crucial para pessoas com sensibilidades alimentares.
Um movimento relevante é o crescente interesse por produtos clean label, que têm como característica a simplicidade e a transparência nas informações sobre os ingredientes. Bióticos clean label, que incluem o uso de culturas bacterianas naturais e prebióticos derivados de fontes vegetais, livres de substâncias artificiais, conservantes ou corantes, têm o apelo de serem “mais puros” e mais alinhados com os princípios de saúde e bem-estar.
Outra tendência importante é a crescente utilização de combinações de diferentes tipos de bióticos em uma única formulação, visando aproveitar os benefícios sinérgicos dessas substâncias para maximizar os efeitos positivos para a saúde e bem-estar geral.
Revolucionando a saúde íntima feminina
Infecções vaginais estão entre os principais problemas de saúde enfrentados pelas mulheres, sendo a vaginose bacteriana e a candidíase vulvovaginal as mais comuns. Elas podem causar desconforto significativo e impactar na qualidade de vida das mulheres.
A IFF Health Sciences lançou no Brasil o HOWARU® Feminine Health, uma solução probiótica inovadora voltada para a saúde da mulher. Este suplemento alimentar combina de forma sinérgica os probióticos Lactobacillus acidophilus La-14™ e Lacticaseibacillus rhamnosus HN001® com lactoferrina bovina, uma combinação inédita reconhecida pela ANVISA, que pode contribuir para a saúde vaginal.